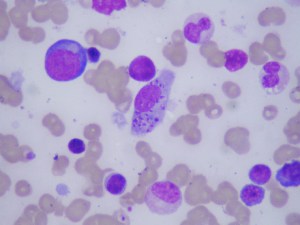
Bone marrow aspirate of a Bangladeshi with fever.

Clinical Vignette 3
A young man from Joydepur, Bangladesh who had worked in Singapore for a year presented with fever for 2 weeks associated with weight loss of 5 kg. The main significant finding on clinical examination was an enlarged spleen and liver. A full blood count was done, showing anemia (Hb = 11.3 g/dL) and mild thrombocytopenia (platelet count = 140 cells/ml). The liver function test was fairly normal except for raised total protein (89 g/L) and hypoalbuminemia (albumin = 28 g/L).
The following abnormal cell was seen on bone marrow aspiration.
What is the diagnosis?
[Updated 18th October 2014]
This young man has visceral leishmaniasis or kala-azar. The blood film showed an infected macrophage filled with the amastigote stage of the parasite. There is only one other infection I know where the blood film appears similar, and that is histoplasmosis, which is caused by a the dimorphic fungus Histoplasma capsulatum. The key difference is that there is an “extra” body within the unicellular organism in the case of Leishmania donovani, which is the kinetoplast.
Visceral leishmaniasis is endemic in many parts of Bangladesh, including Joydepur (see map below – unfortunately, I have forgotten where I obtained the original map).
Treatment is either with pentavalent antimonials or the antifungal drug amphotericin B. We were fortunately able to treat this young man with liposomal amphotericin (ambisome). This is an extremely expensive drug that was quite beyond his means to pay, but fortunately his insurance company relented and consented to pay for his treatment in Singapore.
More about this sandfly-transmitted disease – probably the second most important parasite causing human mortality besides malaria – another time.